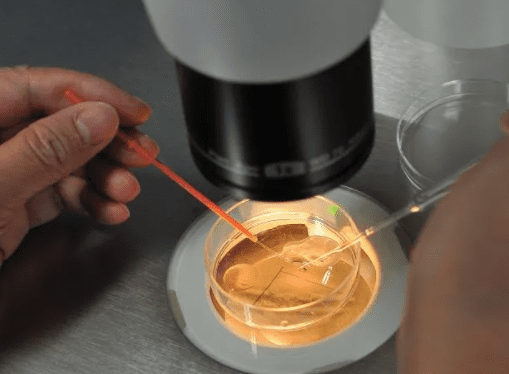

近年来随着生活节奏的加快,越来越多的单身人士选择在泰国进行试管婴儿手术。那么单身在泰国做试管婴儿合法吗?期间需要注意什么呢?以下将从三个方面为您解答。要点1:泰
原标题:身体是否有子宫肌瘤,是否必须在试管前进行治疗?最近中山的刘女士去医院做了第二次怀孕,发现子宫内有123个子宫肌瘤,患者也有严重的贫血,需要尽快进行手术。

随着医疗技术的不断发展,试管婴儿技术已经成为了许多不孕不育家庭的希望。在日本试管婴儿技术同样得到了广泛的应用和发展。然而试管婴儿的费用相对较高,对于一些家庭来说
南京试管婴儿一次就成功的概率因个人情况而异,一般在30%-50%左右。影响成功率的因素包括年龄、卵巢功能、精液质量和胚胎质量等。随着医学技术的不断发展,试管婴儿
原标题:立即做试管,连普通药物排卵针都不知道?排卵针是什么排卵针也称为促排卵针。它是一种女性常用的促进排卵的注射药物。它主要含有FSH(焦点成熟激素)。 LH(

正文:吉尔吉斯斯坦试管医院作为中亚地区领,先的辅助生殖医疗机构,其成功的关键不仅在于先进的医疗设备,更在于其技术团队的强大背景。本文将深入解析吉尔吉斯斯坦试管医
原标题:试管婴儿移植后,注意饮食,并注意每日。试管婴儿移植后应妥善安排进行植入和胚胎更顺畅的发展。 试管婴儿移植后,女性可以多吃蔬菜和富含蛋白质的食物。不宜食用
近年来随着科技的进步和人们对生育问题的关注,试管婴儿(IVF)技术在广州越来越受到欢迎。许多家庭希望通过这项技术实现生育梦想,而怀双胞胎的愿望也随之增加。那么在

私立机构作为试管婴儿服务的重要提供者之一,其费用问题自然成为许多家庭关注的焦点。那么杭州试管私立机构做试管大概多少钱呢?本文将为您详细解析。一、费用构成概览杭州
试管婴儿可以精子子吗?试管婴儿可以精子生子吗在不孕不育家庭中,由于女性的原因有不孕症,还因为男性不育,精子弱等原因导致不孕,那么对于没有精子的男性,借用精子是一






